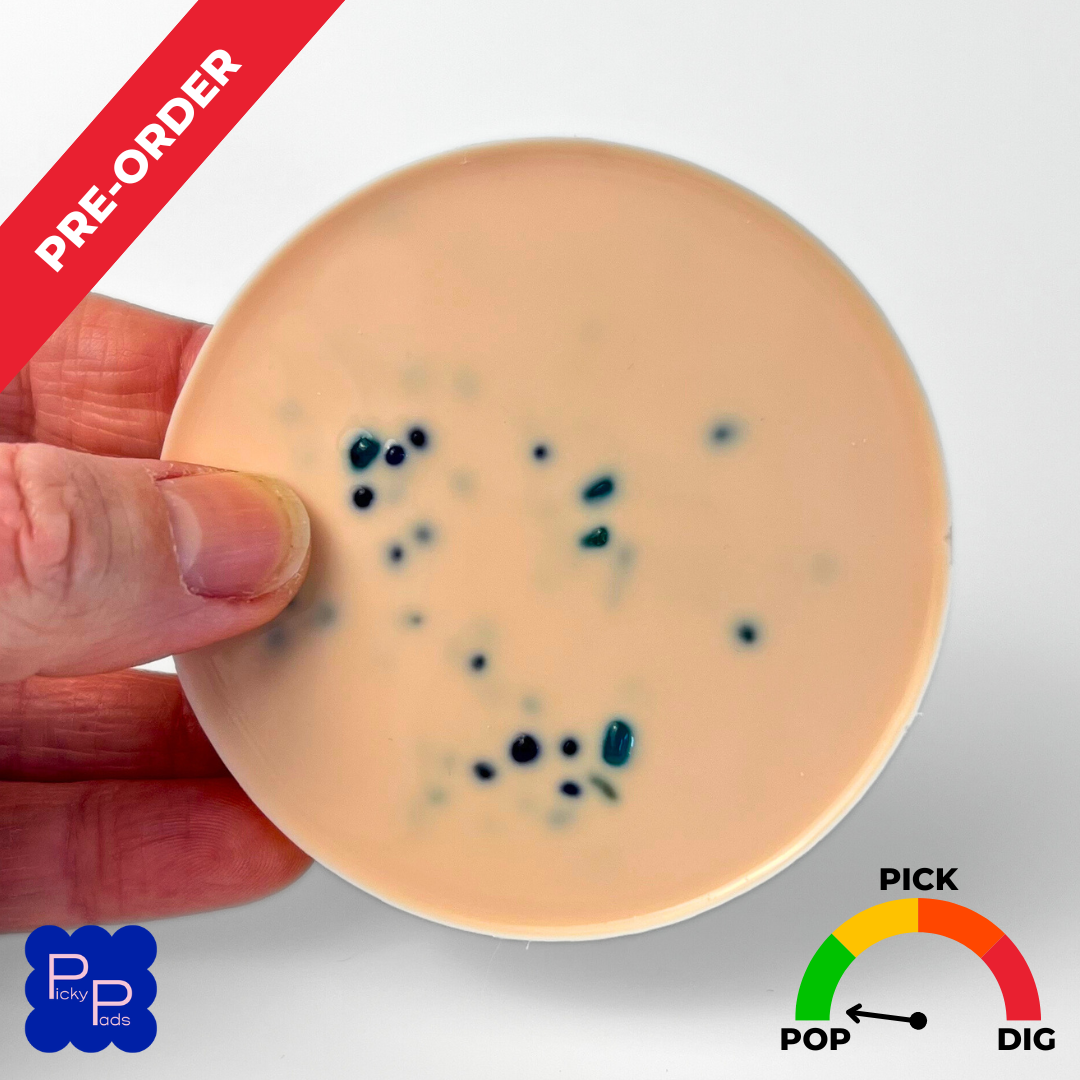
Blackhead Popping Picky Pad – Picky Pads

BLACKHEAD POPPING VIDEOS: FROM ENTERTAINMENT TO EDUCATION
BLACKHEAD POPPING VIDEOS: FROM ENTERTAINMENT TO EDUCATION
The Rise of Blackhead Popping Videos
Blackhead popping videos have taken the world by storm in recent years, gaining millions of views on YouTube and other social media platforms. These videos, which show individuals extracting blackheads from their skin, have sparked both fascination and controversy. At the heart of the debate lies a question: are blackhead popping videos purely entertaining or can they also serve as a tool for education and awareness?
The popularity of blackhead popping videos can be attributed, in part, to the curiosity of viewers. According to dermatologist Dr. Rachel Nazarian, "people are naturally drawn to watching skin care routines and seeing the transformative effects on the skin." This curiosity, combined with the instant gratification and voyeuristic aspect of watching others' skin problems being solved, has fueled the growth of blackhead popping videos.
However, the entertainment aspect of these videos has also raised concerns about their impact on viewers' mental and physical health. Some experts argue that watching these videos can perpetuate unhealthy skin care habits, such as over-extracting blackheads or using ineffective treatments. Dr. Joshua Zeichner, a dermatologist at Mount Sinai Hospital, suggests that viewers should be cautious: "it's essential to remember that every person's skin is unique, and what works for one person may not work for another."
The Educational Potential of Blackhead Popping Videos
Despite the controversy surrounding blackhead popping videos, some creators have harnessed their popularity to educate viewers on proper skin care techniques and the importance of skin health. These videos often feature collaborations with dermatologists or skin care professionals, who share their knowledge and expertise with a wider audience.
Dr. Harprit Singh, a dermatologist at the University of Colorado, emphasizes the potential of blackhead popping videos for education: "by showcasing real-life skin problems and expert insights, these videos can help viewers understand the importance of maintaining a healthy skin care routine." Furthermore, many creators are using their platforms to address common skin concerns, such as acne, rosacea, and hyperpigmentation.
To capitalize on their educational potential, blackhead popping video creators often adhere to the following guidelines:
* Consult with dermatologists or skin care professionals to ensure accuracy and validity of skin care information.
* Provide clear explanations of skin care techniques and treatments used in the videos.
* Encourage responsible skin care practices, such as gentle exfoliation and realist expectations of skin improvement.
Some notable examples of educational blackhead popping videos include:
* Skin Care E.R., a YouTube channel hosted by Dr. Marisa Garshick, a dermatologist with expertise in skin cancer and skin care.
* What's Good Eve, a YouTube channel hosted by Eve, a licensed esthetician who shares her knowledge on skin care and makeup.
* Dermatology 3-1, a YouTube channel hosted by Dr. Jeffrey Epstein, a pediatric dermatologist who explores common skin conditions in children.
Symbiotic Relationship Between Entertainment and Education
It's essential to recognize that blackhead popping videos often occupy a grey area between entertainment and education. While some creators prioritize education, others prioritize entertainment, and some creators strike a balance between the two.
Whether seen as purely entertaining or educational, blackhead popping videos have tapped into a broader cultural obsession with skin care and self-improvement. As Dr. Nazarian notes: "skin care has become a self-care activity, and people are eager to learn and explore new methods and techniques."
Ultimately, the future of blackhead popping videos will depend on how creators choose to balance entertainment and education. By focusing on accurate information and promoting responsible skin care practices, these videos may become an invaluable resource for those seeking to understand and improve their skin.

Related Post

WARNING: The Dark Side of Blackhead Popping Videos

The Rise of Big Blackhead Popping Videos: A Fascinating Phenomenon of the Digital Age

THE BUSTED PREP SCHOOLS OF TELL CITY: EXPOSING THE DARK SIDE OF AFFLUENCE

The Seminole County Inmate Files: A Gripping Journey into Crime and Punishment

